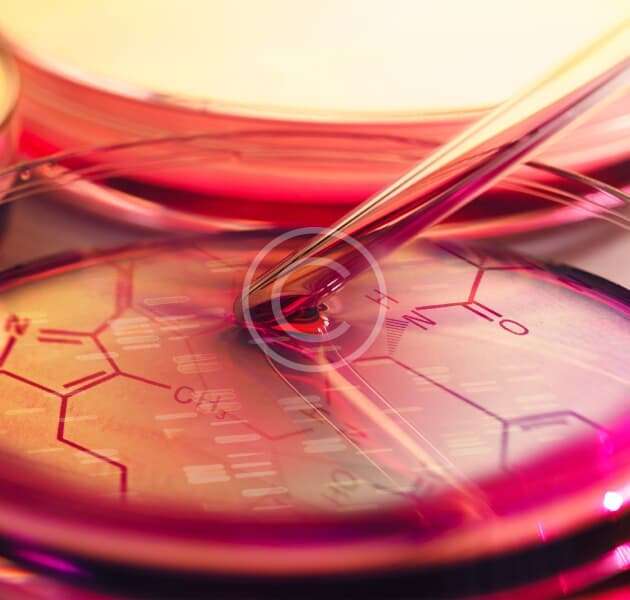

Physician is dedicated to providing expert care and advanced treatments for every patient.

Our team delivers compassionate, tailored care that focuses on your unique health needs.


Discover our hospital’s patient-first care with a guided demo that shows our advanced tools in action.